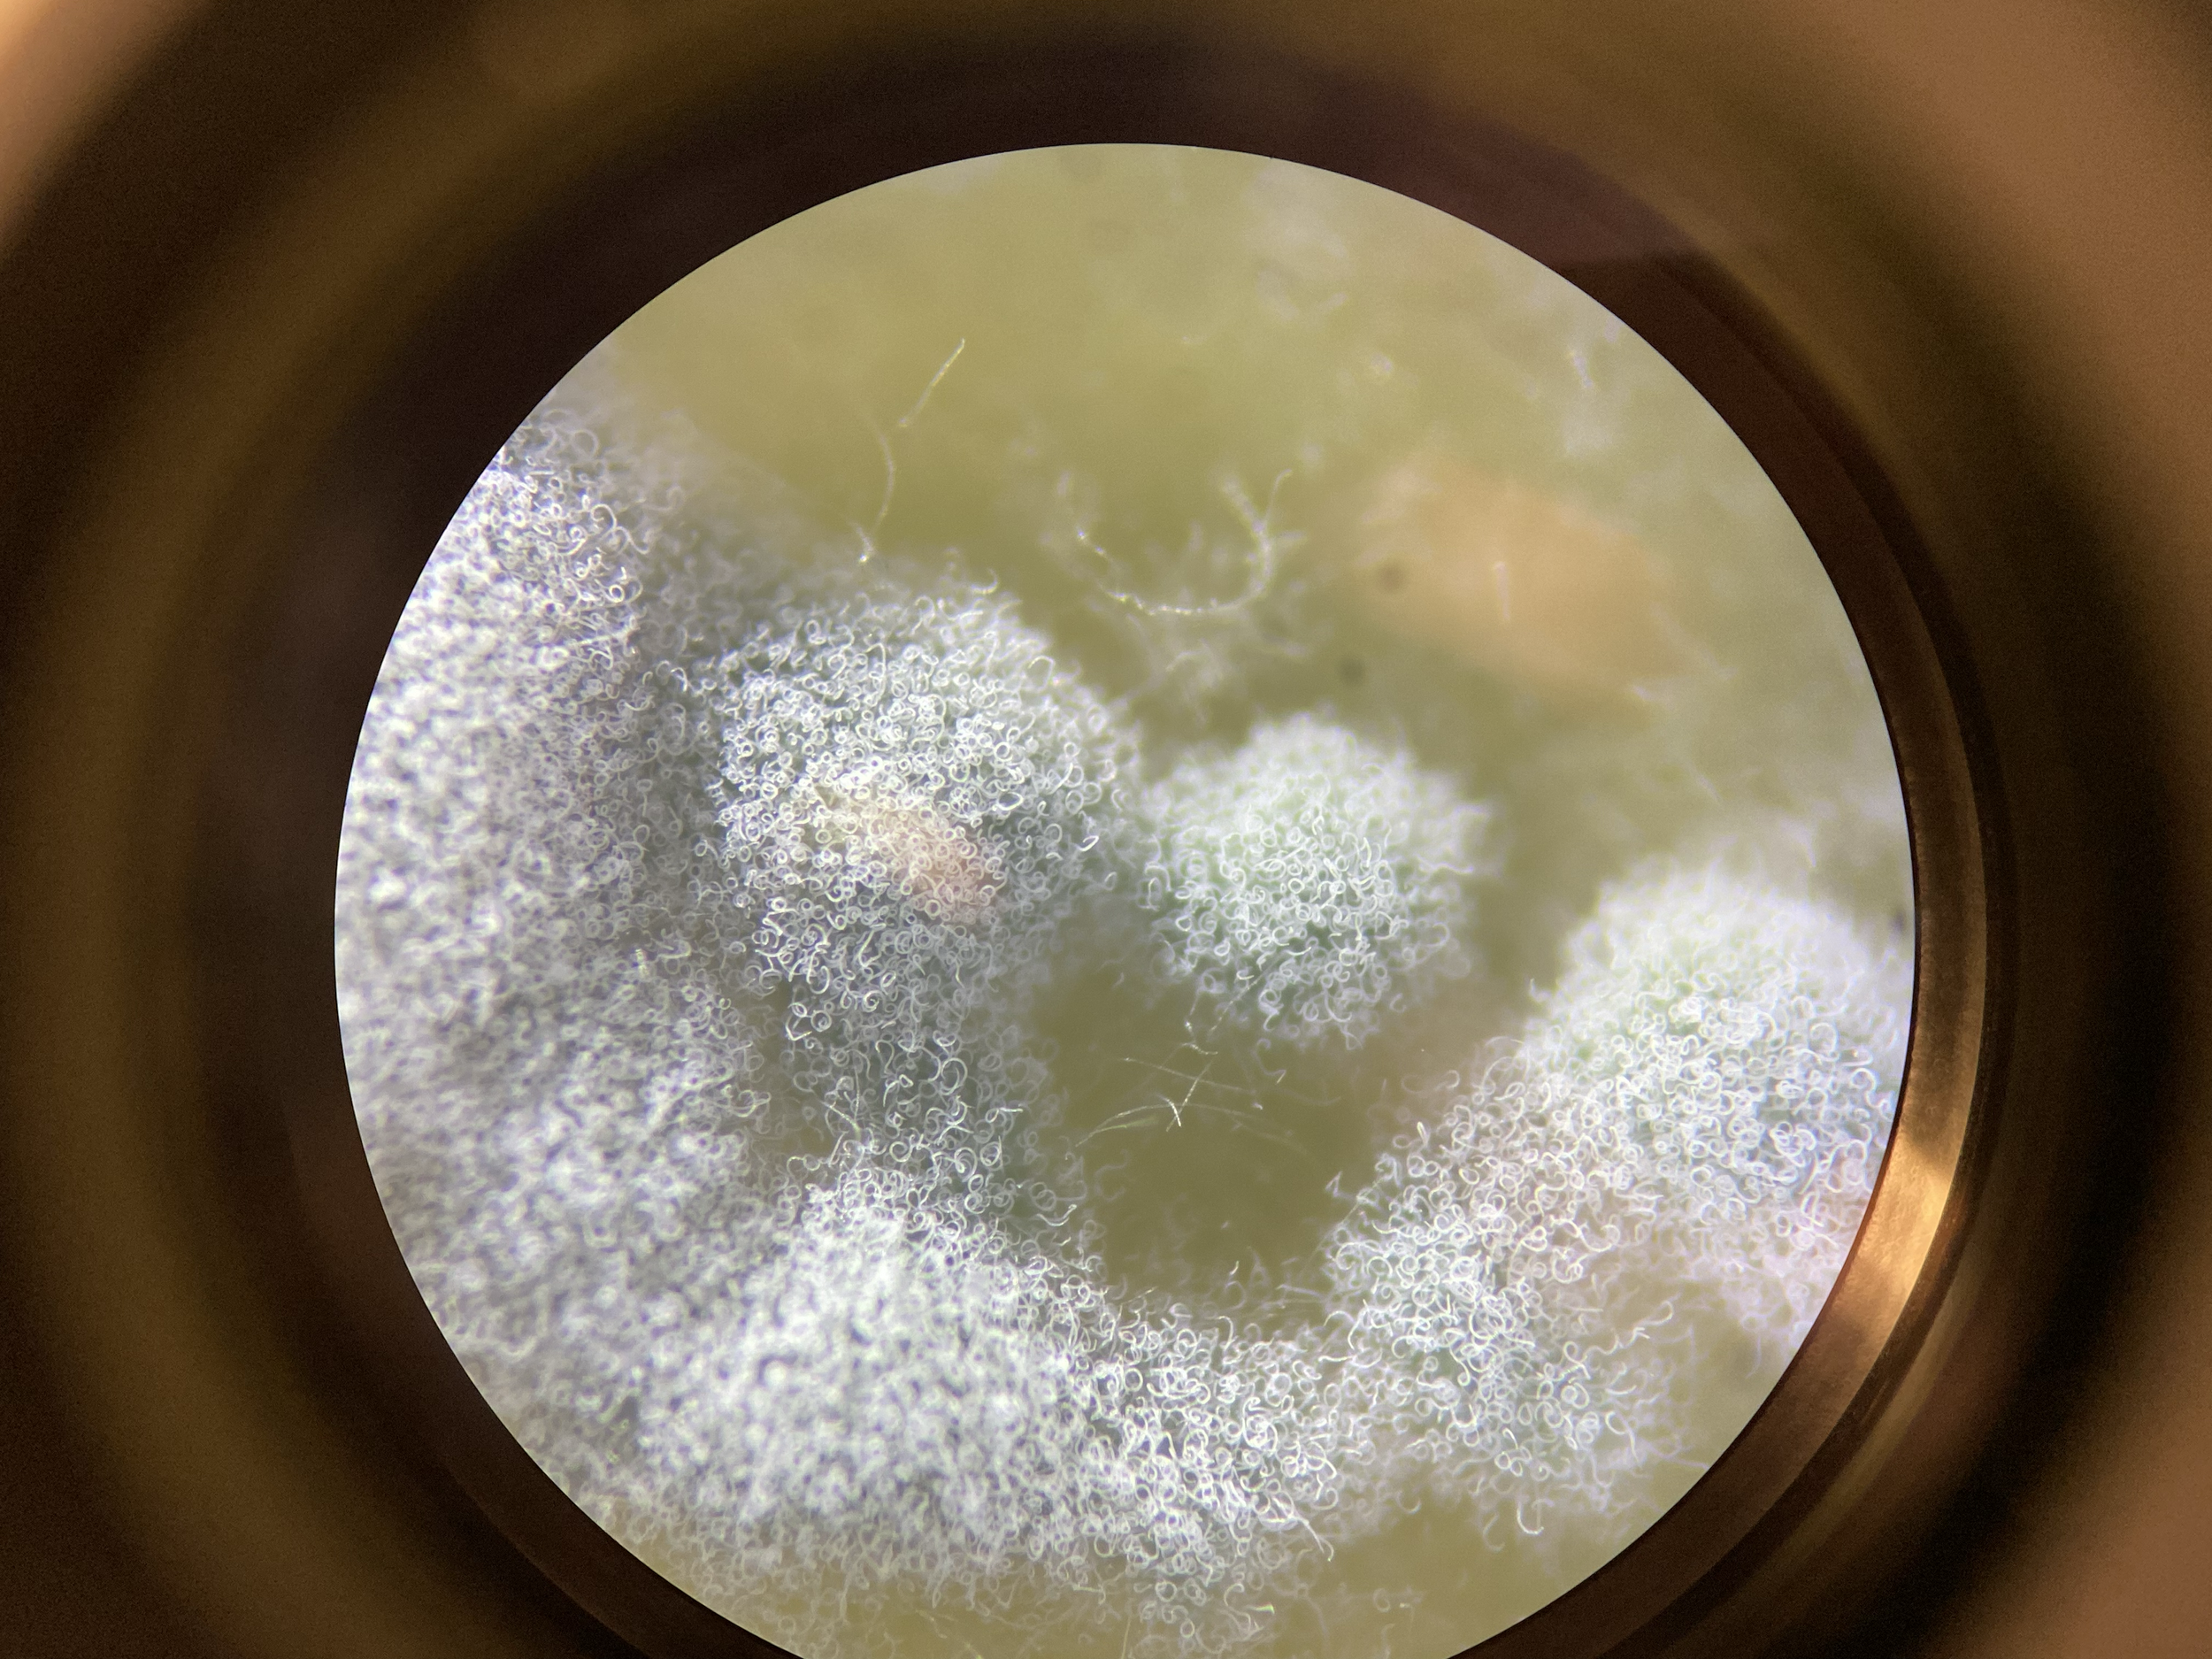
tempImageIryC4L.png
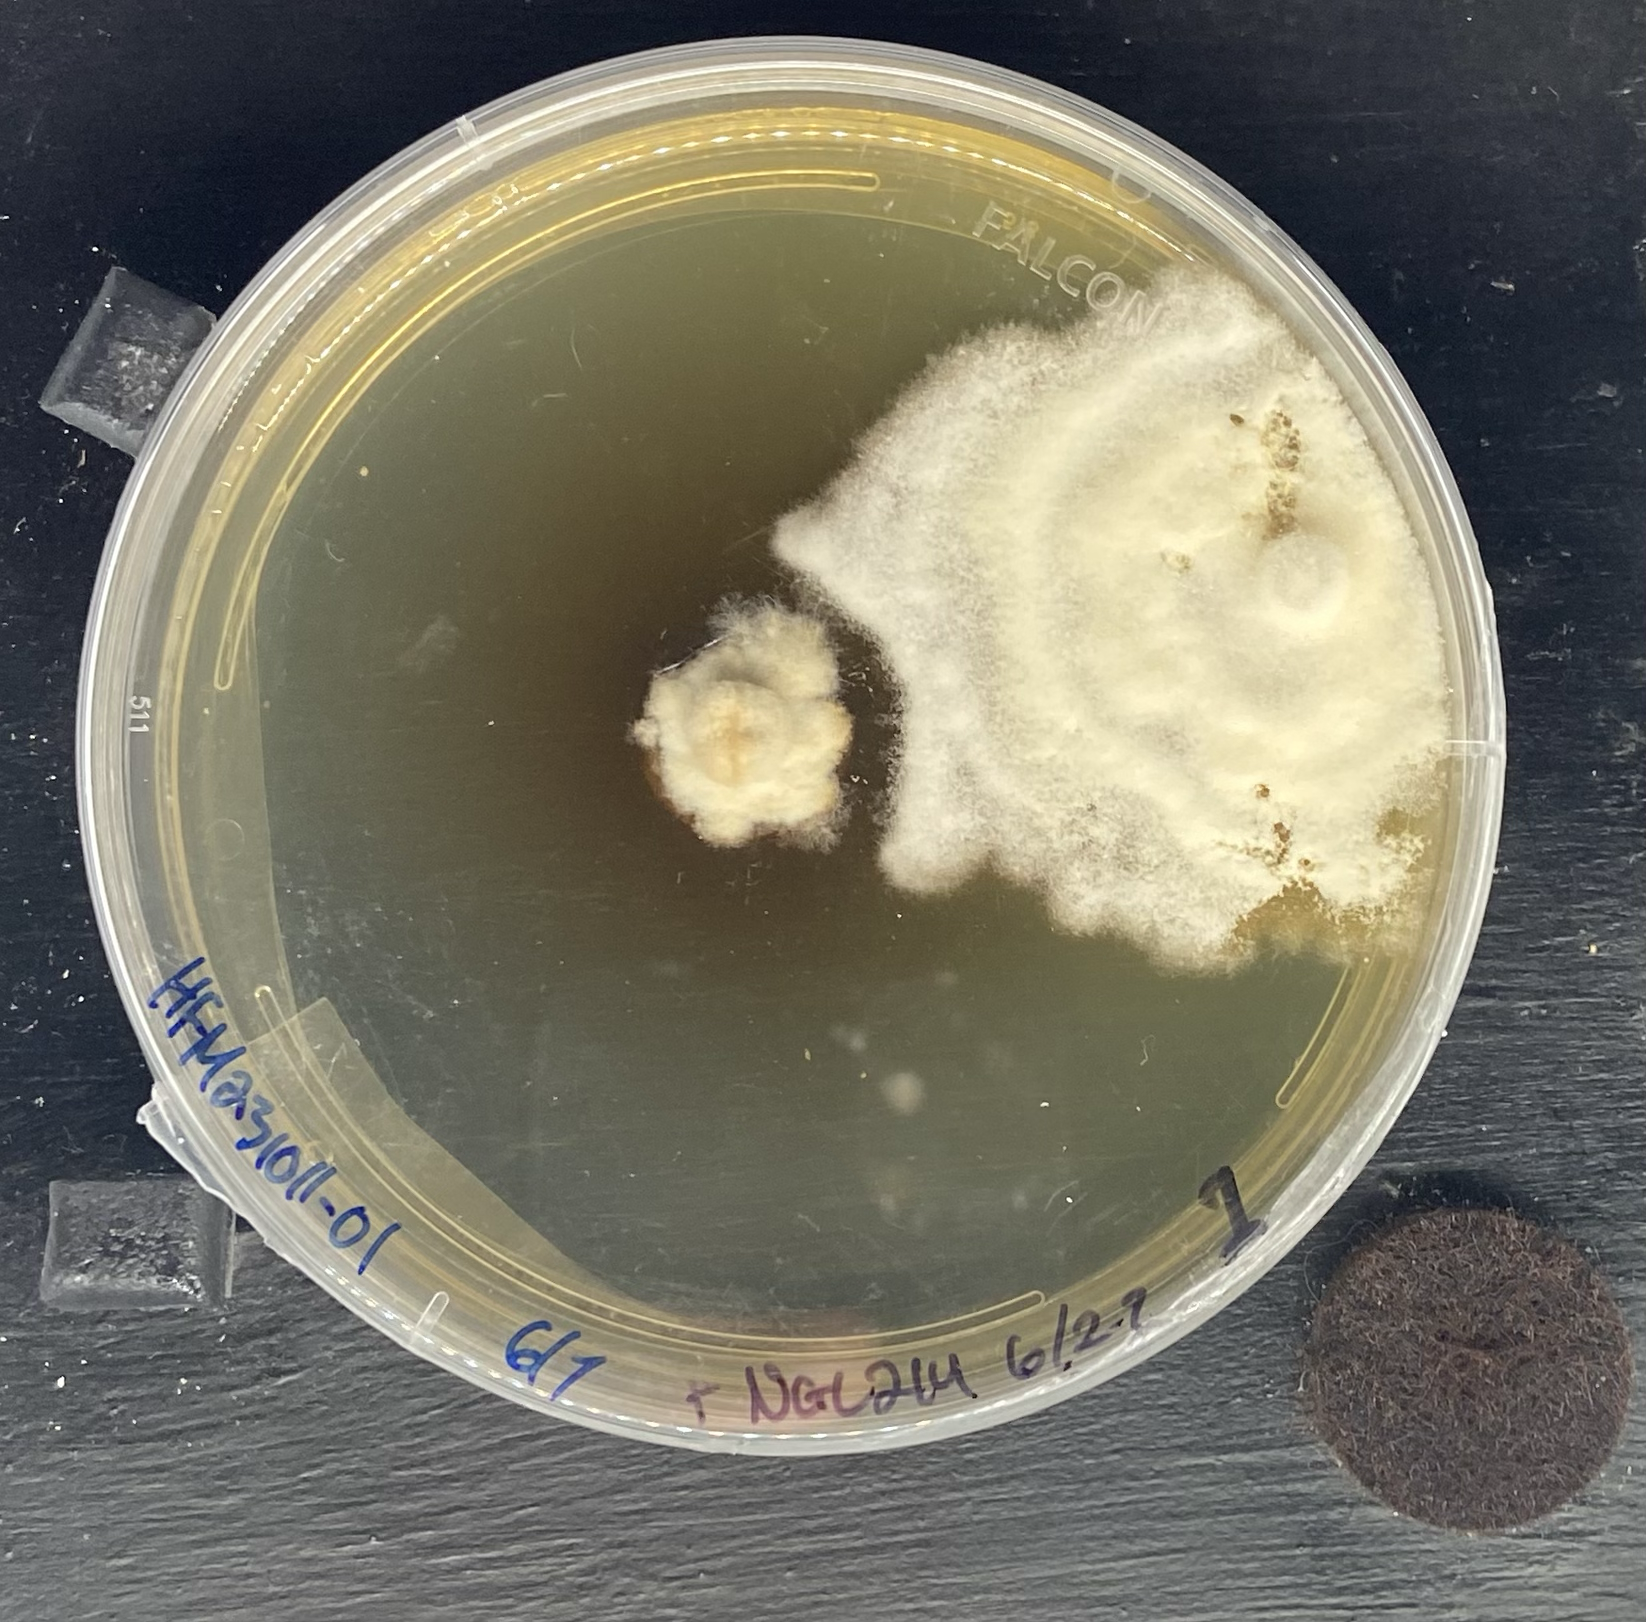
tempImageiwAFoX.png
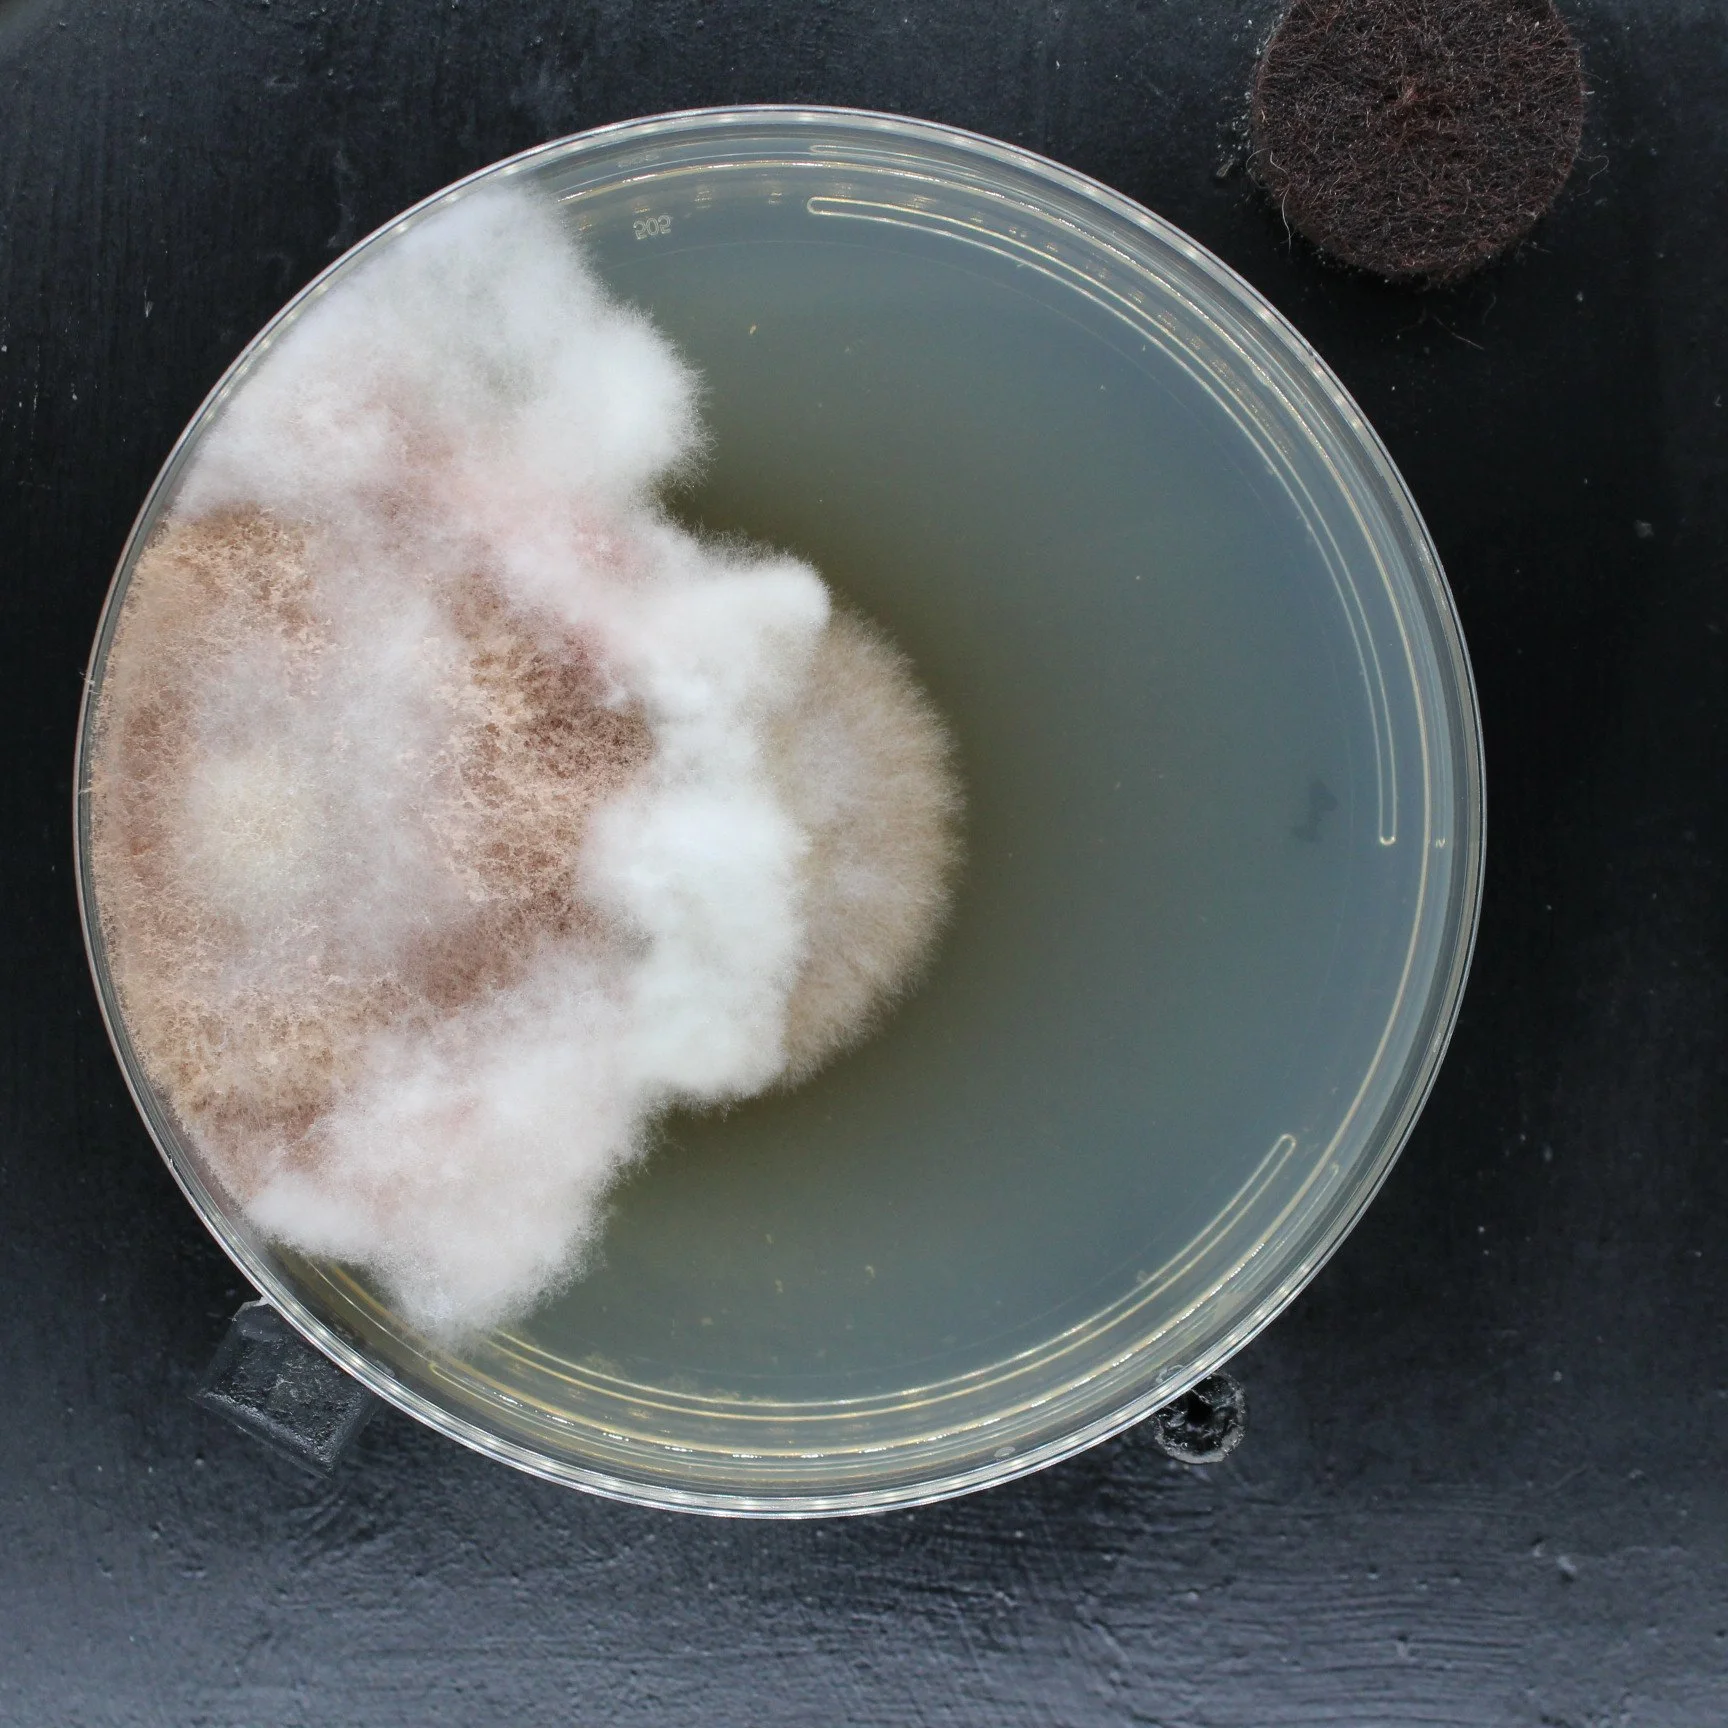
IMG_0841 3.JPG
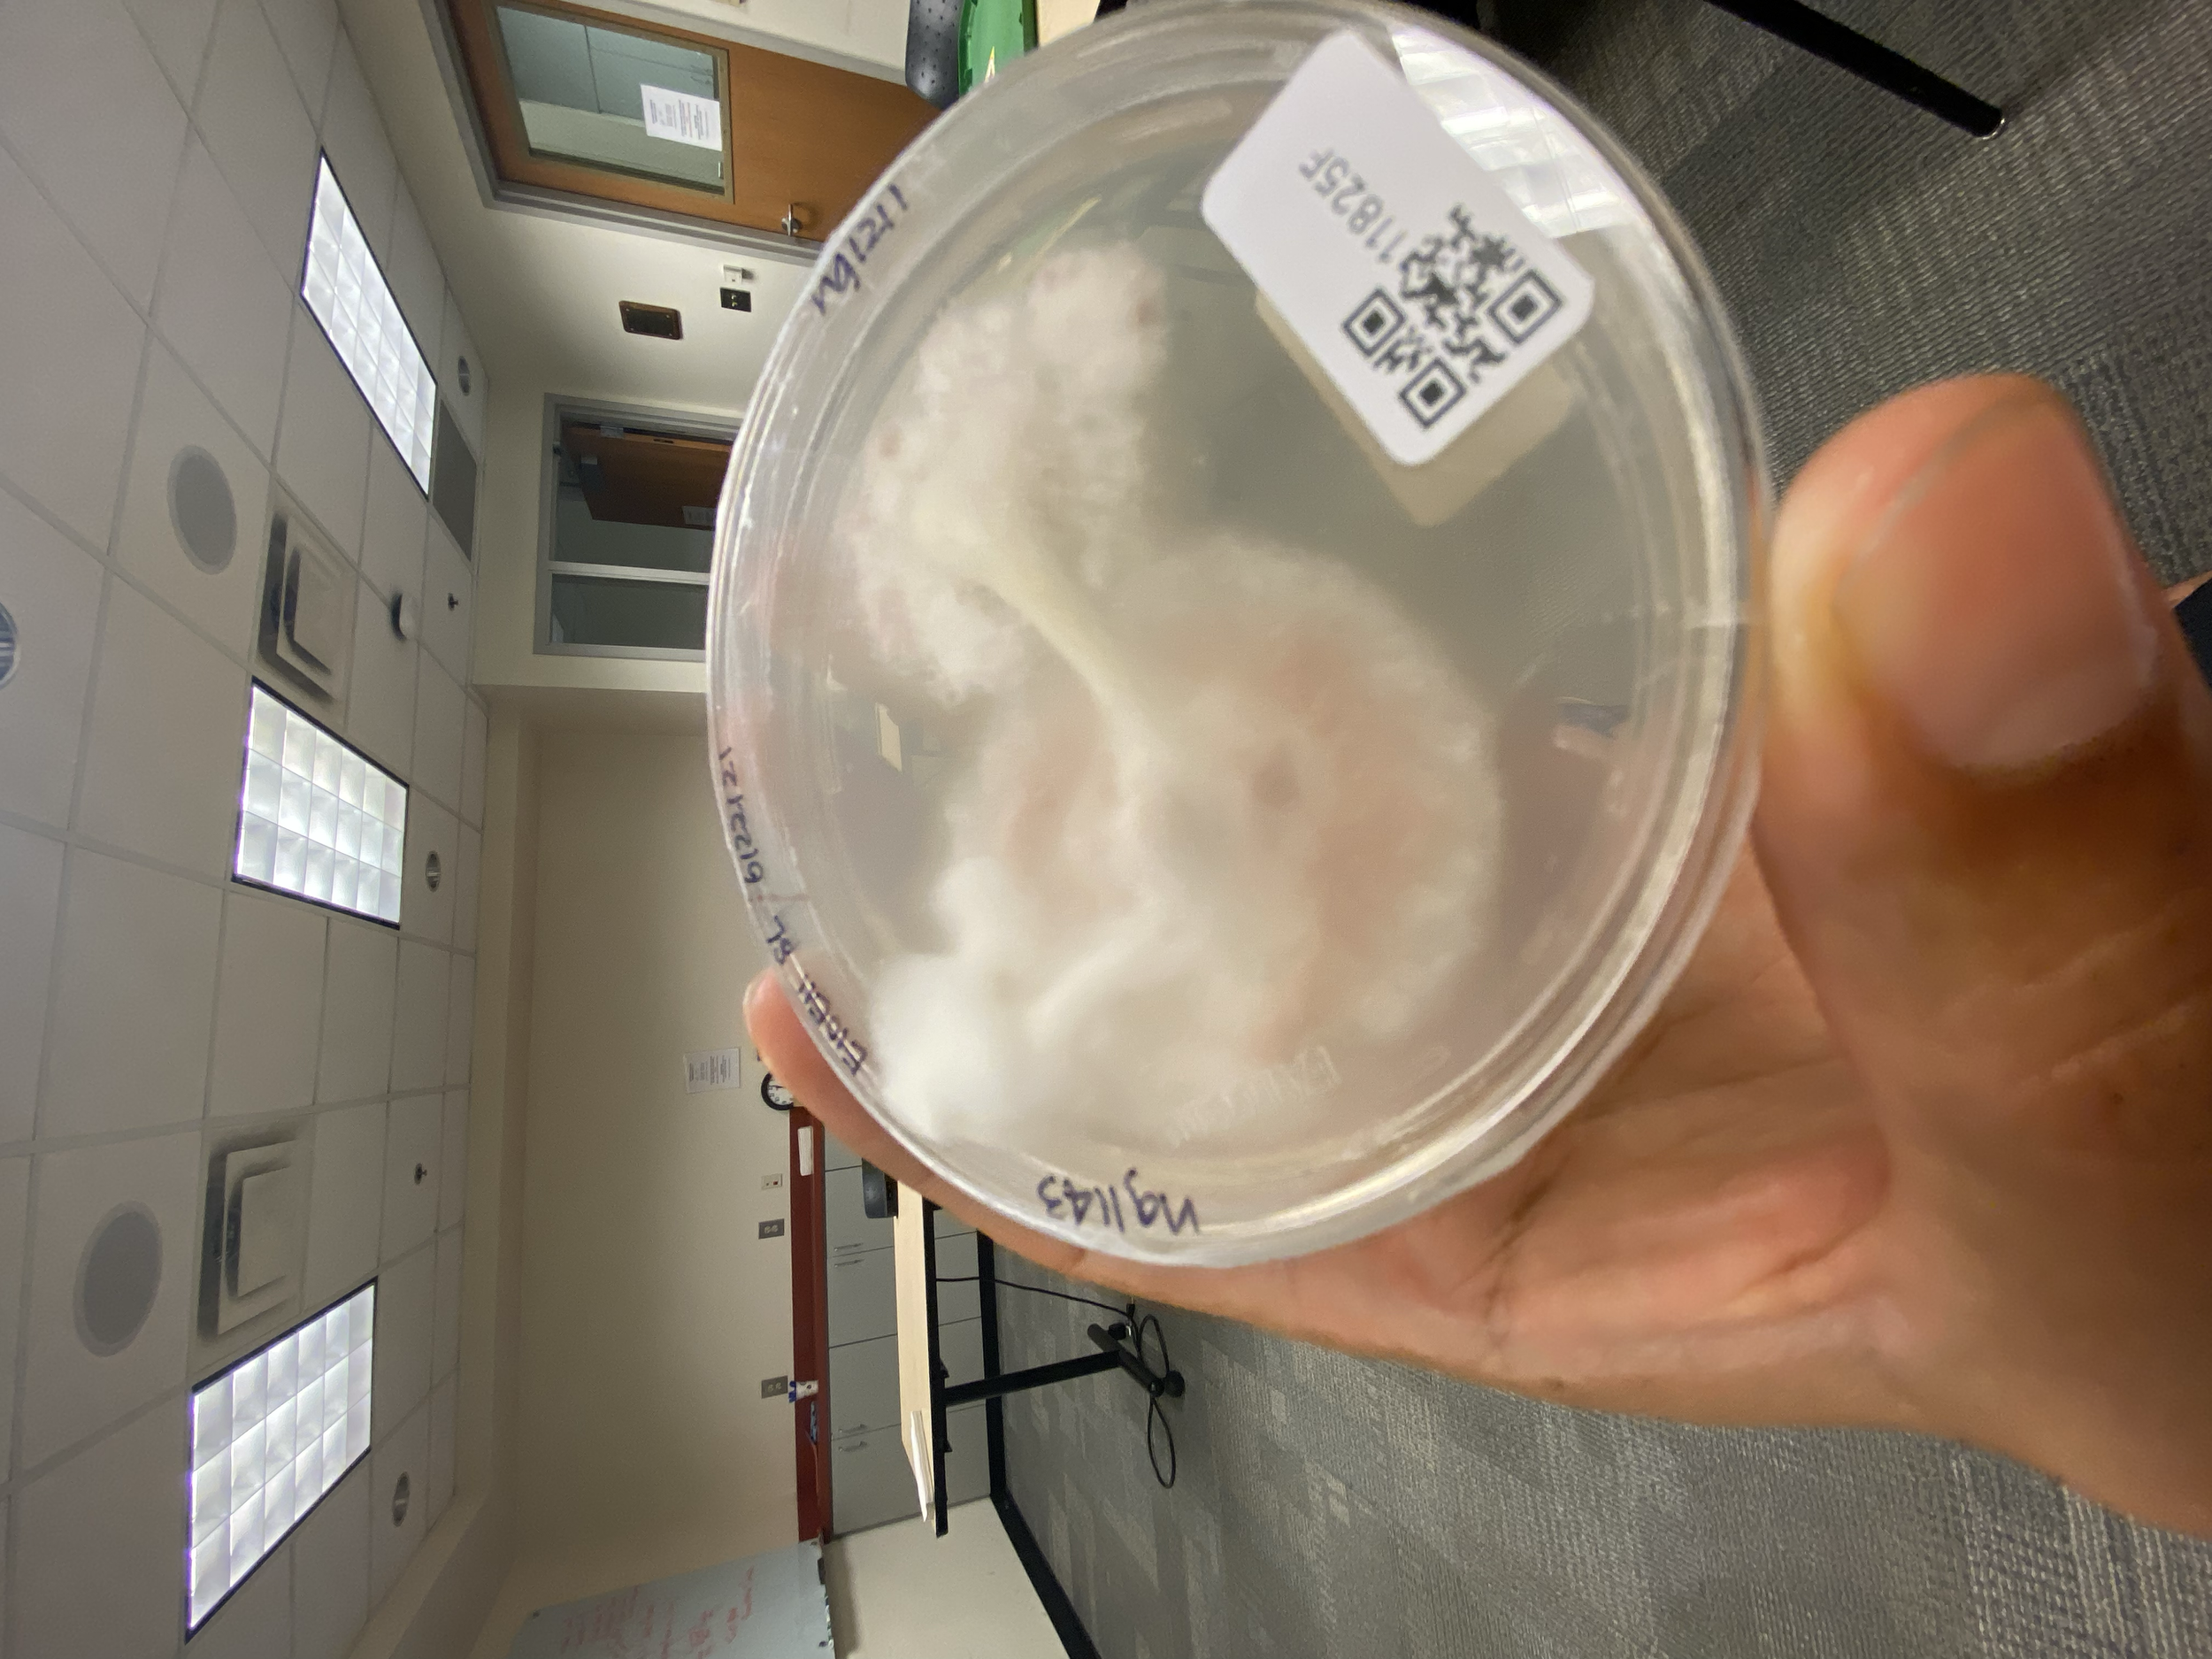
tempImagedRxqTq.png
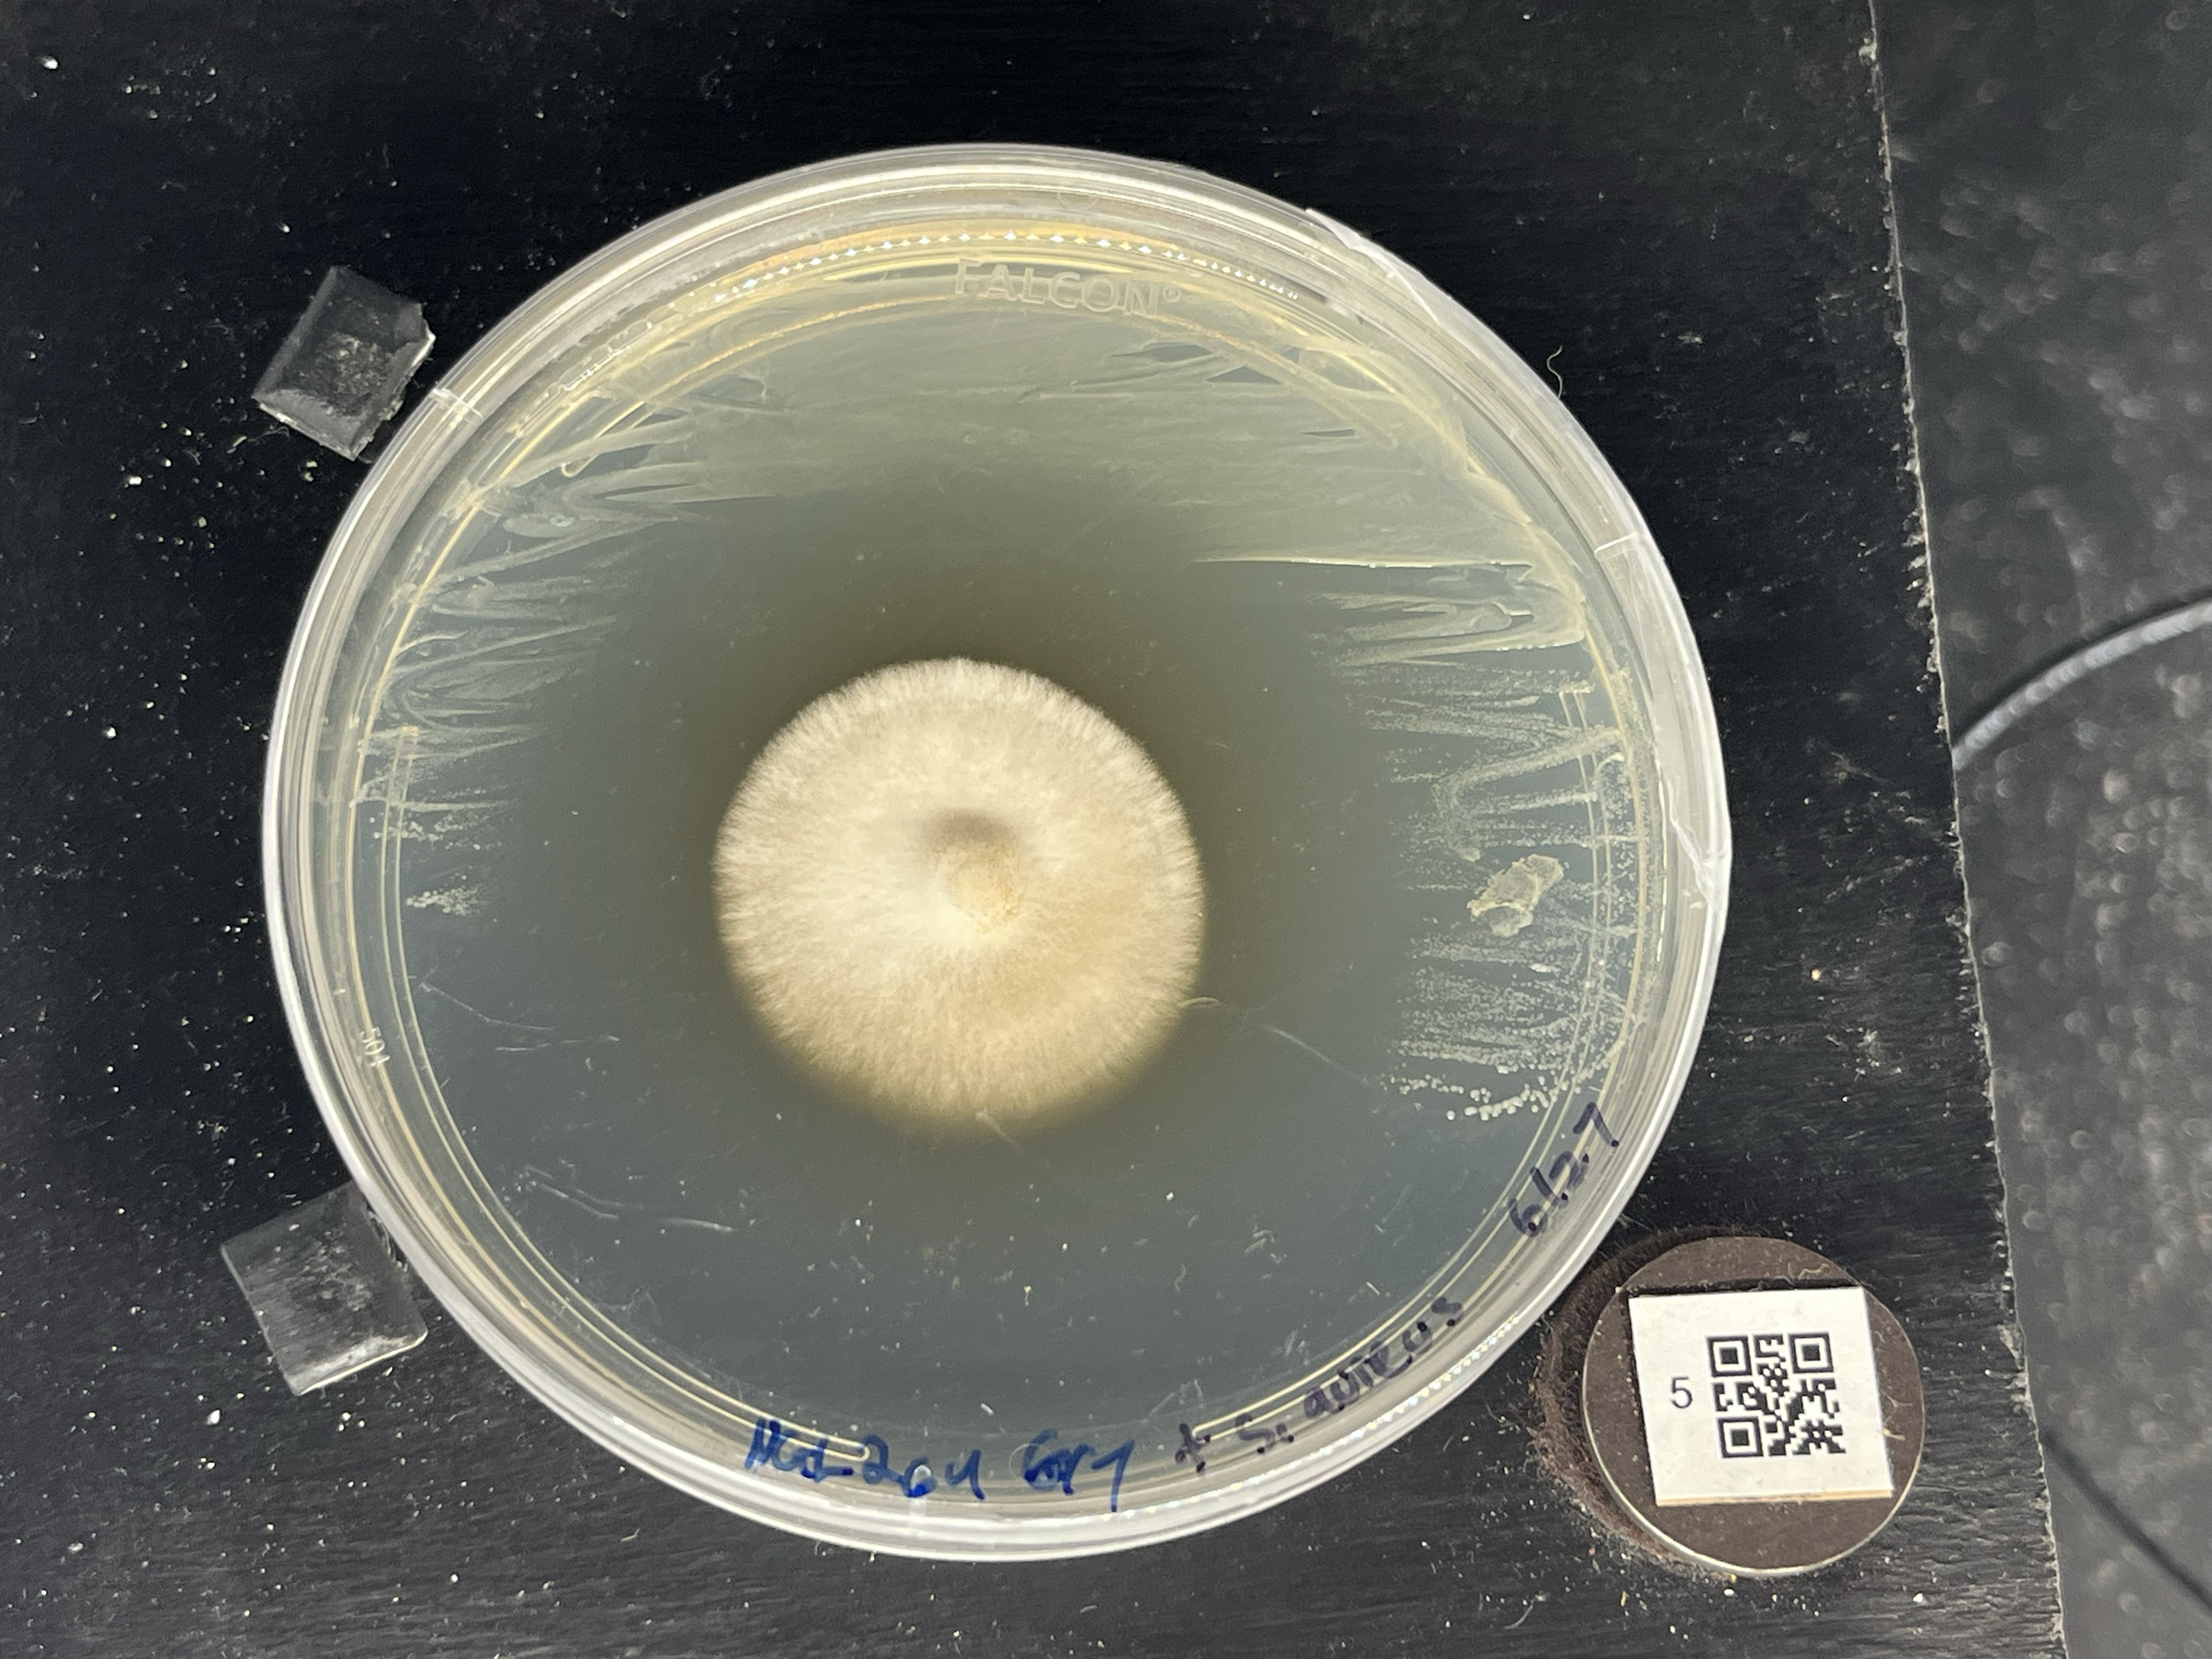
tempImagecsXlmo.png

Photos

Videos
Leafcutter ants traffic